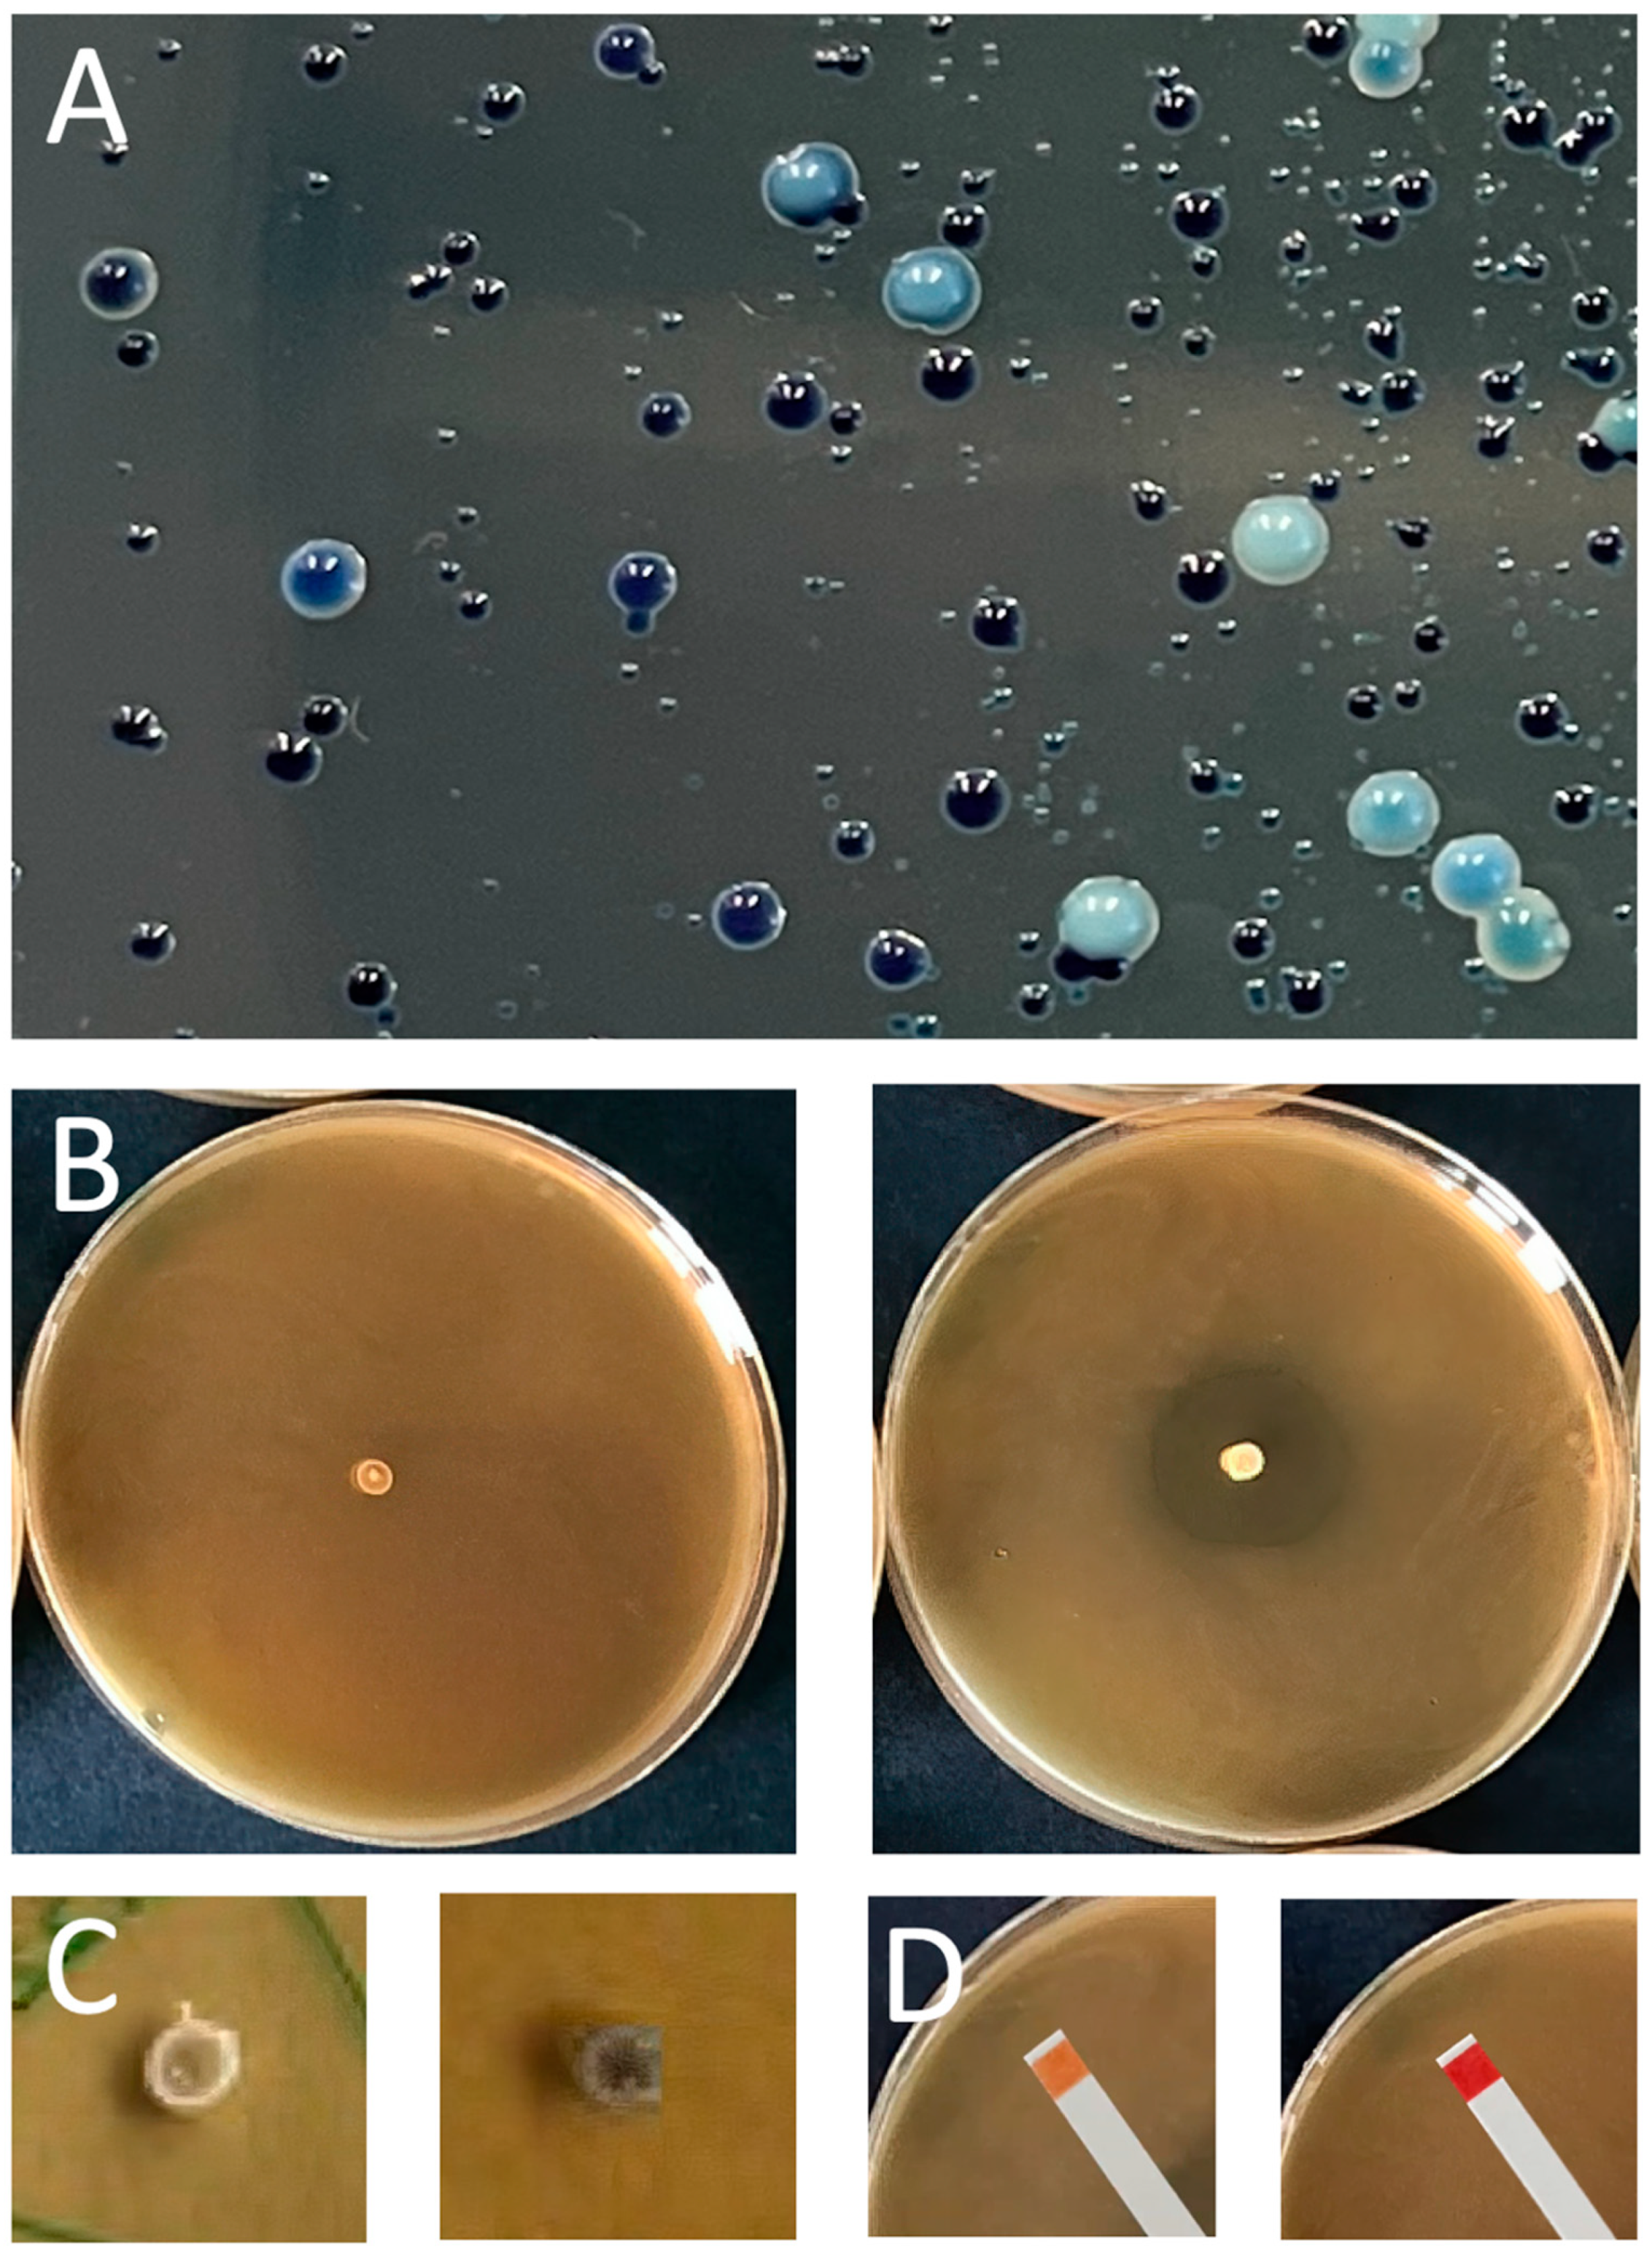

Protective Cultures in Food Products: From Science to Market
Abstract
1. Introduction
2. Antibacterial Properties
3. Isolation and Validation of protective LAB and Bacteriocins
4. Industrial Production of Protective Cultures, Bacteriocins, and Their Actual Imitations
5. The Legal Use of Protection Cultures and Bacteriocins in the European Union
6. The Legal Use of Protection Cultures and Bacteriocins in the United States of America
7. The Legal Use of Protection Cultures and Bacteriocins in Latin America
8. The Legal Use of Protection Cultures and Bacteriocins in Asia
9. Market Overview
10. Conclusions
Author Contributions
Funding
Data Availability Statement
Acknowledgments
Conflicts of Interest
References
- FAO. The State of Food Security and Nutrition in the World 2022; FAO: Rome, Italy, 2022; ISBN 978-92-5-136499-4. [Google Scholar]
- Kirk, M.D.; Pires, S.M.; Black, R.E.; Caipo, M.; Crump, J.A.; Devleesschauwer, B.; Döpfer, D.; Fazil, A.; Fischer-Walker, C.L.; Hald, T.; et al. World Health Organization Estimates of the Global and Regional Disease Burden of 22 Foodborne Bacterial, Protozoal, and Viral Diseases, 2010: A Data Synthesis. PLoS Med. 2015, 12, e1001921. [Google Scholar] [CrossRef]
- Scallan, E.; Hoekstra, R.M.; Angulo, F.J.; Tauxe, R.V.; Widdowson, M.-A.; Roy, S.L.; Jones, J.L.; Griffin, P.M. Foodborne Illness Acquired in the United States—Major Pathogens. Emerg. Infect. Dis. 2011, 17, 7–15. [Google Scholar] [CrossRef] [PubMed]
- Pires, S.M.; Desta, B.N.; Mughini-Gras, L.; Mmbaga, B.T.; Fayemi, O.E.; Salvador, E.M.; Gobena, T.; Majowicz, S.E.; Hald, T.; Hoejskov, P.S.; et al. Burden of Foodborne Diseases: Think Global, Act Local. Curr. Opin. Food Sci. 2021, 39, 152–159. [Google Scholar] [CrossRef] [PubMed]
- Xue, L.; Liu, G.; Parfitt, J.; Liu, X.; Van Herpen, E.; Stenmarck, Å.; O’Connor, C.; Östergren, K.; Cheng, S. Missing Food, Missing Data? A Critical Review of Global Food Losses and Food Waste Data. Environ. Sci. Technol. 2017, 51, 6618–6633. [Google Scholar] [CrossRef]
- Food Wastage Footprint. Food Wastage Footprint Full-Cost Accounting: Final Report; Food Wastage Footprint: Rome, Italy, 2014; ISBN 978-92-5-108512-7. [Google Scholar]
- Rahman, S. (Ed.) Handbook of Food Preservation, 2nd ed.; Food Science and Technology; CRC Press: Boca Raton, FL, USA, 2007; ISBN 978-1-57444-606-7. [Google Scholar]
- Zhong, Y.; Wu, L.; Chen, X.; Huang, Z.; Hu, W. Effects of Food-Additive-Information on Consumers’ Willingness to Accept Food with Additives. Int. J. Environ. Res. Public Health 2018, 15, 2394. [Google Scholar] [CrossRef]
- Hutkins, R.W. Microbiology and Technology of Fermented Foods, 2nd ed.; IFT PRESS Series; Wiley Blackwell: Hoboken, NJ, USA, 2019; ISBN 978-1-119-02756-0. [Google Scholar]
- Cheung, C. Managing Food Storage in the Roman Empire. Quat. Int. 2021, 597, 63–75. [Google Scholar] [CrossRef]
- Metchnikoff, É. The Prolongation of Life- Optimistic Studies; The Knickerbocker Press: New York, NY, USA; London, UK, 1908. [Google Scholar]
- Vasiljevic, T.; Shah, N.P. Probiotics—From Metchnikoff to Bioactives. Int. Dairy. J. 2008, 18, 714–728. [Google Scholar] [CrossRef]
- Hansen, E.B. Commercial Bacterial Starter Cultures for Fermented Foods of the Future. Int. J. Food Microbiol. 2002, 78, 119–131. [Google Scholar] [CrossRef]
- Ibrahim, S.A.; Ayivi, R.D.; Zimmerman, T.; Siddiqui, S.A.; Altemimi, A.B.; Fidan, H.; Esatbeyoglu, T.; Bakhshayesh, R.V. Lactic Acid Bacteria as Antimicrobial Agents: Food Safety and Microbial Food Spoilage Prevention. Foods 2021, 10, 3131. [Google Scholar] [CrossRef]
- Ben Said, L.; Gaudreau, H.; Dallaire, L.; Tessier, M.; Fliss, I. Bioprotective Culture: A New Generation of Food Additives for the Preservation of Food Quality and Safety. Ind. Biotechnol. 2019, 15, 138–147. [Google Scholar] [CrossRef]
- Jay, J.M. Microorganisms in Fresh Ground Meats: The Relative Safety of Products with Low versus High Numbers. Meat Sci. 1996, 43, 59–66. [Google Scholar] [CrossRef]
- Mellefont, L.A.; McMeekin, T.A.; Ross, T. Effect of Relative Inoculum Concentration on Listeria Monocytogenes Growth in Co-Culture. Int. J. Food Microbiol. 2008, 121, 157–168. [Google Scholar] [CrossRef]
- Jameson, J.E. A Discussion of the Dynamics of Salmonella Enrichment. J. Hyg. 1962, 60, 193–207. [Google Scholar] [CrossRef]
- Bolívar, A.; Tarlak, F.; Costa, J.C.C.P.; Cejudo-Gómez, M.; Bover-Cid, S.; Zurera, G.; Pérez-Rodríguez, F. A New Expanded Modelling Approach for Investigating the Bioprotective Capacity of Latilactobacillus Sakei CTC494 against Listeria Monocytogenes in Ready-to-Eat Fish Products. Food Res. Int. 2021, 147, 110545. [Google Scholar] [CrossRef]
- Serra-Castelló, C.; Costa, J.C.C.P.; Jofré, A.; Bolívar, A.; Pérez-Rodríguez, F.; Bover-Cid, S. A Mathematical Model to Predict the Antilisteria Bioprotective Effect of Latilactobacillus Sakei CTC494 in Vacuum Packaged Cooked Ham. Int. J. Food Microbiol. 2022, 363, 109491. [Google Scholar] [CrossRef]
- Cornu, M.; Billoir, E.; Bergis, H.; Beaufort, A.; Zuliani, V. Modeling Microbial Competition in Food: Application to the Behavior of Listeria Monocytogenes and Lactic Acid Flora in Pork Meat Products. Food Microbiol. 2011, 28, 639–647. [Google Scholar] [CrossRef] [PubMed]
- Rigali, S.; Titgemeyer, F.; Barends, S.; Mulder, S.; Thomae, A.W.; Hopwood, D.A.; van Wezel, G.P. Feast or Famine: The Global Regulator DasR Links Nutrient Stress to Antibiotic Production by Streptomyces. EMBO Rep. 2008, 9, 670–675. [Google Scholar] [CrossRef]
- Molloy, S. From Start to Finish for Streptomyces. Nat. Rev. Microbiol. 2008, 6, 569. [Google Scholar] [CrossRef]
- Nothaft, H.; Rigali, S.; Boomsma, B.; Swiatek, M.; McDowall, K.J.; van Wezel, G.P.; Titgemeyer, F. The Permease Gene NagE2 Is the Key to N. -Acetylglucosamine Sensing and Utilization in Streptomyces Coelicolor and Is Subject to Multi-Level Control. Mol. Microbiol. 2010, 75, 1133–1144. [Google Scholar] [CrossRef]
- Van Bergeijk, D.A.; Terlouw, B.R.; Medema, M.H.; van Wezel, G.P. Ecology and Genomics of Actinobacteria: New Concepts for Natural Product Discovery. Nat. Rev. Microbiol. 2020, 18, 546–558. [Google Scholar] [CrossRef]
- Lindgren, S.E.; Dobrogosz, W.J. Antagonistic Activities of Lactic Acid Bacteria in Food and Feed Fermentations. FEMS Microbiol. Lett. 1990, 87, 149–164. [Google Scholar] [CrossRef] [PubMed]
- Van de Guchte, M.M.; Serror, P.P.; Chervaux, C.; Smokvina, T.; Ehrlich, S.S.; Maguin, E. Stress Responses in Lactic Acid Bacteria. Antonie Van Leeuwenhoek 2002, 82, 187. [Google Scholar] [CrossRef] [PubMed]
- Lund, P.A.; De Biase, D.; Liran, O.; Scheler, O.; Mira, N.P.; Cetecioglu, Z.; Fernández, E.N.; Bover-Cid, S.; Hall, R.; Sauer, M.; et al. Understanding How Microorganisms Respond to Acid PH Is Central to Their Control and Successful Exploitation. Front. Microbiol. 2020, 11, 556140. [Google Scholar] [CrossRef] [PubMed]
- Hirshfield, I.N.; Terzulli, S.; O’Byrne, C. Weak Organic Acids: A Panoply of Effects on Bacteria. Sci. Prog. 2003, 86, 245–270. [Google Scholar] [CrossRef] [PubMed]
- Wadhwa, N.; Berg, H.C. Bacterial Motility: Machinery and Mechanisms. Nat. Rev. Microbiol. 2022, 20, 161–173. [Google Scholar] [CrossRef]
- Nakajima, H.; Toba, T.; Ito, A.; Kudo, S.; Sato, S.; Sato, Y. The Screening of Hydrogen Peroxide-Producing Lactic Acid Bacteria and Their Application to Inactivating Psychrotrophic Food-Borne Pathogens. Curr. Microbiol. 2003, 47, 231–236. [Google Scholar] [CrossRef]
- Hertzberger, R.; Arents, J.; Dekker, H.L.; Pridmore, R.D.; Gysler, C.; Kleerebezem, M.; de Mattos, M.J.T. H2O2 Production in Species of the Lactobacillus Acidophilus Group: A Central Role for a Novel NADH-Dependent Flavin Reductase. Appl. Environ. Microbiol. 2014, 80, 2229–2239. [Google Scholar] [CrossRef]
- Khurshid, H. Antimicrobial Properties of Hydrogen Peroxide and Potash Alum Alone and in Combination against Clinical Bacterial Isolates. Pure Appl. Biol. 2019, 8, 2238–2247. [Google Scholar] [CrossRef]
- Andrés, C.M.C.; Pérez de la Lastra, J.M.; Juan, C.A.; Plou, F.J.; Pérez-Lebeña, E. Chemistry of Hydrogen Peroxide Formation and Elimination in Mammalian Cells, and Its Role in Various Pathologies. Stresses 2022, 2, 256–274. [Google Scholar] [CrossRef]
- Lanciotti, R.; Patrignani, F.; Bagnolini, F.; Guerzoni, M.E.; Gardini, F. Evaluation of Diacetyl Antimicrobial Activity against Escherichia Coli, Listeria Monocytogenes and Staphylococcus Aureus. Food Microbiol. 2003, 20, 537–543. [Google Scholar] [CrossRef]
- Jay, J.M. Antimicrobial Properties of Diacetylt. Appl. Environ. Microbiol. 1982, 44, 525–532. [Google Scholar] [CrossRef]
- Bjeldanes, L.F.; Chew, H. Mutagenicity of 1,2-Dicarbonyl Compounds: Maltol, Kojic Acid, Diacetyl and Related Substances. Mutat. Res. Genet. Toxicol. 1979, 67, 367–371. [Google Scholar] [CrossRef]
- Whittaker, P.; Clarke, J.J.; San, R.H.C.; Begley, T.H.; Dunkel, V.C. Evaluation of the Butter Flavoring Chemical Diacetyl and a Fluorochemical Paper Additive for Mutagenicity and Toxicity Using the Mammalian Cell Gene Mutation Assay in L5178Y Mouse Lymphoma Cells. Food Chem. Toxicol. 2008, 46, 2928–2933. [Google Scholar] [CrossRef]
- Shibamoto, T. Diacetyl: Occurrence, Analysis, and Toxicity. J. Agric. Food Chem. 2014, 62, 4048–4053. [Google Scholar] [CrossRef]
- Park, D.H. Effects of Carbon Dioxide on Metabolite Production and Bacterial Communities during Kimchi Fermentation. Biosci. Biotechnol. Biochem. 2018, 82, 1234–1242. [Google Scholar] [CrossRef]
- Martley, F.G.; Crow, V.L. Open Texture in Cheese: The Contributions of Gas Production by Microorganisms and Cheese Manufacturing Practices. J. Dairy Res. 1996, 63, 489–507. [Google Scholar] [CrossRef]
- De Vuyst, L.; Vandamme, E.J. Antimicrobial Potential of Lactic Acid Bacteria. In Bacteriocins of Lactic Acid Bacteria: Microbiology, Genetics and Applications; De Vuyst, L., Vandamme, E.J., Eds.; Springer: Boston, MA, USA, 1994; pp. 91–142. ISBN 978-1-4615-2668-1. [Google Scholar]
- Schaefer, L.; Auchtung, T.A.; Hermans, K.E.; Whitehead, D.; Borhan, B.; Britton, R.A. The Antimicrobial Compound Reuterin (3-Hydroxypropionaldehyde) Induces Oxidative Stress via Interaction with Thiol Groups. Microbiology 2010, 156, 1589–1599. [Google Scholar] [CrossRef]
- Vimont, A.; Fernandez, B.; Ahmed, G.; Fortin, H.-P.; Fliss, I. Quantitative Antifungal Activity of Reuterin against Food Isolates of Yeasts and Moulds and Its Potential Application in Yogurt. Int. J. Food Microbiol. 2019, 289, 182–188. [Google Scholar] [CrossRef]
- Cotter, P.D.; Ross, R.P.; Hill, C. Bacteriocins—A Viable Alternative to Antibiotics? Nat. Rev. Microbiol. 2013, 11, 95–105. [Google Scholar] [CrossRef]
- Heilbronner, S.; Krismer, B.; Brötz-Oesterhelt, H.; Peschel, A. The Microbiome-Shaping Roles of Bacteriocins. Nat. Rev. Microbiol. 2021, 19, 726–739. [Google Scholar] [CrossRef]
- Alvarez-Sieiro, P.; Montalbán-López, M.; Mu, D.; Kuipers, O.P. Bacteriocins of Lactic Acid Bacteria: Extending the Family. Appl. Microbiol. Biotechnol. 2016, 100, 2939–2951. [Google Scholar] [CrossRef] [PubMed]
- Silva, C.C.G.; Silva, S.P.M.; Ribeiro, S.C. Application of Bacteriocins and Protective Cultures in Dairy Food Preservation. Front. Microbiol. 2018, 9, 594. [Google Scholar] [CrossRef] [PubMed]
- Kjos, M.; Nes, I.F.; Diep, D.B. Mechanisms of Resistance to Bacteriocins Targeting the Mannose Phosphotransferase System. Appl. Env. Microbiol. 2011, 77, 3335–3342. [Google Scholar] [CrossRef] [PubMed]
- Gargis, A.S.; O’Rourke, A.-L.D.; Sloan, G.L.; Simmonds, R.S. Prevalence and Acquisition of the Genes for Zoocin A and Zoocin A Resistance in Streptococcus Equi Subsp. Zooepidemicus. J. Mol. Evol. 2009, 68, 498–505. [Google Scholar] [CrossRef] [PubMed]
- Van Heel, A.J.; de Jong, A.; Song, C.; Viel, J.H.; Kok, J.; Kuipers, O.P. BAGEL4: A User-Friendly Web Server to Thoroughly Mine RiPPs and Bacteriocins. Nucleic Acids Res. 2018, 46, W278–W281. [Google Scholar] [CrossRef]
- Balasubramanian, S.; Chen, J.; Wigneswaran, V.; Bang-Berthelsen, C.H.; Jensen, P.R. Droplet-Based Microfluidic High Throughput Screening of Corynebacterium Glutamicum for Efficient Heterologous Protein Production and Secretion. Front. Bioeng. Biotechnol. 2021, 9, 668531. [Google Scholar] [CrossRef]
- Iacumin, L.; Cappellari, G.; Colautti, A.; Comi, G. Listeria Monocytogenes Survey in Cubed Cooked Ham Packaged in Modified Atmosphere and Bioprotective Effect of Selected Lactic Acid Bacteria. Microorganisms 2020, 8, 898. [Google Scholar] [CrossRef]
- Chaillou, S.; Christieans, S.; Rivollier, M.; Lucquin, I.; Champomier-Vergès, M.C.; Zagorec, M. Quantification and Efficiency of Lactobacillus Sakei Strain Mixtures Used as Protective Cultures in Ground Beef. Meat Sci. 2014, 97, 332–338. [Google Scholar] [CrossRef]
- Vescovo, M.; Scolari, G.; Zacconi, C. Inhibition of Listeria Innocua Growth by Antimicrobial-Producing Lactic Acid Cultures in Vacuum-Packed Cold-Smoked Salmon. Food Microbiol. 2006, 23, 689–693. [Google Scholar] [CrossRef]
- Leroi, F.; Cornet, J.; Chevalier, F.; Cardinal, M.; Coeuret, G.; Chaillou, S.; Joffraud, J.-J. Selection of Bioprotective Cultures for Preventing Cold-Smoked Salmon Spoilage. Int. J. Food Microbiol. 2015, 213, 79–87. [Google Scholar] [CrossRef]
- Coelho, M.C.; Silva, C.C.G.; Ribeiro, S.C.; Dapkevicius, M.L.N.E.; Rosa, H.J.D. Control of Listeria Monocytogenes in Fresh Cheese Using Protective Lactic Acid Bacteria. Int. J. Food Microbiol. 2014, 191, 53–59. [Google Scholar] [CrossRef]
- Agriopoulou, S.; Stamatelopoulou, E.; Sachadyn-Król, M.; Varzakas, T. Lactic Acid Bacteria as Antibacterial Agents to Extend the Shelf Life of Fresh and Minimally Processed Fruits and Vegetables: Quality and Safety Aspects. Microorganisms 2020, 8, 952. [Google Scholar] [CrossRef]
- Köckerling, E.; Karrasch, L.; Schweitzer, A.; Razum, O.; Krause, G. Public Health Research Resulting from One of the World’s Largest Outbreaks Caused by Entero-Hemorrhagic Escherichia Coli in Germany 2011: A Review. Front. Public Health 2017, 5, 332. [Google Scholar] [CrossRef]
- Wei, H.; Wolf, G.; Hammes, W.P. Indigenous Microorganisms from Iceberg Lettuce with Adherence and Antagonistic Potential for Use as Protective Culture. Innov. Food Sci. Emerg. Technol. 2006, 7, 294–301. [Google Scholar] [CrossRef]
- Rodgers, S. Novel Applications of Live Bacteria in Food Services: Probiotics and Protective Cultures. Trends Food Sci. Technol. 2008, 19, 188–197. [Google Scholar] [CrossRef]
- Makhal, S.; Kanawjia, S.K.; Giri, A. Effect of MicroGARD on Keeping Quality of Direct Acidified Cottage Cheese. J. Food Sci. Technol. 2015, 52, 936–943. [Google Scholar] [CrossRef]
- Quinto, E.J.; Marín, J.M.; Schaffner, D.W. Effect of the Competitive Growth of Lactobacillus Sakei MN on the Growth Kinetics of Listeria Monocytogenes Scott A in Model Meat Gravy. Food Control. 2016, 63, 34–45. [Google Scholar] [CrossRef]
- Mejlholm, O.; Dalgaard, P. Modelling and Predicting the Simultaneous Growth of Listeria Monocytogenes and Psychrotolerant Lactic Acid Bacteria in Processed Seafood and Mayonnaise-Based Seafood Salads. Food Microbiol. 2015, 46, 1–14. [Google Scholar] [CrossRef]
- Zhao, S.; Hao, X.; Yang, F.; Wang, Y.; Fan, X.; Wang, Y. Antifungal Activity of Lactobacillus plantarum ZZUA493 and Its Application to Extend the Shelf Life of Chinese Steamed Buns. Foods 2022, 11, 195. [Google Scholar] [CrossRef] [PubMed]
- Lauková, A.; Focková, V.; Pogány Simonová, M. Enterococcus Mundtii Isolated from Slovak Raw Goat Milk and Its Bacteriocinogenic Potential. Int. J. Environ. Res. Public Health 2020, 17, 9504. [Google Scholar] [CrossRef]
- Tulini, F.L.; Hymery, N.; Haertlé, T.; Le Blay, G.; De Martinis, E.C.P. Screening for Antimicrobial and Proteolytic Activities of Lactic Acid Bacteria Isolated from Cow, Buffalo and Goat Milk and Cheeses Marketed in the Southeast Region of Brazil. J. Dairy Res. 2016, 83, 115–124. [Google Scholar] [CrossRef] [PubMed]
- Chen, J.; Pang, H.; Wang, L.; Ma, C.; Wu, G.; Liu, Y.; Guan, Y.; Zhang, M.; Qin, G.; Tan, Z. Bacteriocin-Producing Lactic Acid Bacteria Strains with Antimicrobial Activity Screened from Bamei Pig Feces. Foods 2022, 11, 709. [Google Scholar] [CrossRef] [PubMed]
- Tuntisuwanno, N.; Charernjiratrakul, W.; Bovornruengroj, N.; Borvornruengroj, P. Selection of Biopreservative-Produced Lactic Acid Bacteria from Chilled Seafood Products. CMUJNS 2014, 13, 459–468. [Google Scholar] [CrossRef]
- Gustaw, K.; Michalak, M.; Polak-Berecka, M.; Waśko, A. Isolation and Characterization of a New Fructophilic Lactobacillus Plantarum FPL Strain from Honeydew. Ann. Microbiol. 2018, 68, 459–470. [Google Scholar] [CrossRef] [PubMed]
- Lee, H.M.; Lee, Y. A Differential Medium for Lactic Acid-Producing Bacteria in a Mixed Culture. Lett. Appl. Microbiol. 2008, 46, 676–681. [Google Scholar] [CrossRef]
- Ricciardi, A.; Parente, E.; Tramutola, A.; Guidone, A.; Ianniello, R.G.; Pavlidis, D.; Tsakalidou, E.; Zotta, T. Evaluation of a Differential Medium for the Preliminary Identification of Members of the Lactobacillus Plantarum and Lactobacillus Casei Groups. Ann. Microbiol. 2015, 65, 1649–1658. [Google Scholar] [CrossRef]
- Galat, A.; Dufresne, J.; Combrisson, J.; Thépaut, J.; Boumghar-Bourtchai, L.; Boyer, M.; Fourmestraux, C. Novel Method Based on Chromogenic Media for Discrimination and Selective Enumeration of Lactic Acid Bacteria in Fermented Milk Products. Food Microbiol. 2016, 55, 86–94. [Google Scholar] [CrossRef]
- Fijan, S.; Šulc, D.; Steyer, A. Study of the In Vitro Antagonistic Activity of Various Single-Strain and Multi-Strain Probiotics against Escherichia Coli. Int. J. Environ. Res. Public Health 2018, 15, 1539. [Google Scholar] [CrossRef]
- Aymerich, T.; Martín, B.; Garriga, M.; Hugas, M. Microbial Quality and Direct PCR Identification of Lactic Acid Bacteria and Nonpathogenic Staphylococci from Artisanal Low-Acid Sausages. Appl. Environ. Microbiol. 2003, 69, 12. [Google Scholar] [CrossRef]
- Ben Amor, K.; Vaughan, E.E.; de Vos, W.M. Advanced Molecular Tools for the Identification of Lactic Acid Bacteria. J. Nutr. 2007, 137, 741S–747S. [Google Scholar] [CrossRef]
- Yadav, M.K.; Singh, B.; Tiwari, S.K. Comparative Analysis of Inhibition-Based and Indicator-Independent Colorimetric Assay for Screening of Bacteriocin-Producing Lactic Acid Bacteria. Probiotics Antimicrob. Proteins 2021, 9, 687–695. [Google Scholar] [CrossRef]
- Adeniyi, B.A.; Adetoye, A.; Ayeni, F.A. Antibacterial Activities of Lactic Acid Bacteria Isolated from Cow Faeces against Potential Enteric Pathogens. Afr. Health Sci. 2015, 15, 888–895. [Google Scholar] [CrossRef]
- Vijay Simha, B.; Sood, S.K.; Kumariya, R.; Garsa, A.K. Simple and Rapid Purification of Pediocin PA-1 from Pediococcus Pentosaceous NCDC 273 Suitable for Industrial Application. Microbiol. Res. 2012, 167, 544–549. [Google Scholar] [CrossRef]
- Hettiarachchi, S.A.; Lee, S.-J.; Lee, Y.; Kwon, Y.-K.; Zoysa, M.D.; Moon, S.; Jo, E.; Kim, E.; Kang, D.-H.; Heo, S.-J.; et al. A Rapid and Efficient Screening Method for Antibacterial Compound-Producing Bacteria. J. Microbiol. Biotechnol. 2017, 27, 1441–1448. [Google Scholar] [CrossRef]
- Abrunhosa, L.; Guimaraes, A.; Venancio, A. Antifungal Effect of Organic Acids from Lactic Acid Bacteria on Penicillium Nordicum. Food Addit. Contam. Part A Chem. Anal. Control. 2018, 35, 1803–1818. [Google Scholar]
- Tomás, M.S.J.; Claudia Otero, M.; Ocaña, V.; Elena Nader-Macías, M. Production of Antimicrobial Substances by Lactic Acid Bacteria I: Determination of Hydrogen Peroxide. In Methods in Molecular Biology; Spencer, J.F.T., Ed.; Public Health Microbiology: Methods and Protocols; Humana Press: Totowa, NJ, USA, 2004; Volume 268, pp. 337–346. ISBN 978-1-59259-766-6. [Google Scholar]
- Tomás, M.S.J.; Bru, E.; Nader-Macías, M.E. Comparison of the Growth and Hydrogen Peroxide Production by Vaginal Probiotic Lactobacilli under Different Culture Conditions. Am. J. Obstet. Gynecol. 2003, 188, 35–44. [Google Scholar] [CrossRef]
- Muñoz-Atienza, E.; Gómez-Sala, B.; Araújo, C.; Campanero, C.; del Campo, R.; Hernández, P.E.; Herranz, C.; Cintas, L.M. Antimicrobial Activity, Antibiotic Susceptibility and Virulence Factors of Lactic Acid Bacteria of Aquatic Origin Intended for Use as Probiotics in Aquaculture. BMC Microbiol. 2013, 13, 15. [Google Scholar] [CrossRef]
- Sirichoat, A.; Flórez, A.B.; Vázquez, L.; Buppasiri, P.; Panya, M.; Lulitanond, V.; Mayo, B. Antibiotic Susceptibility Profiles of Lactic Acid Bacteria from the Human Vagina and Genetic Basis of Acquired Resistances. Int. J. Med. Sci. 2020, 21, 2594. [Google Scholar] [CrossRef]
- Panthee, S.; Paudel, A.; Blom, J.; Hamamoto, H.; Sekimizu, K. Complete Genome Sequence of Weissella Hellenica 0916-4-2 and Its Comparative Genomic Analysis. Front. Microbiol. 2019, 10, 1619. [Google Scholar] [CrossRef]
- Rodríguez, J.M.; Martínez, M.I.; Kok, J. Pediocin PA-1, a Wide-Spectrum Bacteriocin from Lactic Acid Bacteria. Crit. Rev. Food Sci. Nutr. 2002, 42, 91–121. [Google Scholar] [CrossRef]
- Yi, L.; Qi, T.; Hong, Y.; Deng, L.; Zeng, K. Screening of Bacteriocin-Producing Lactic Acid Bacteria in Chinese Homemade Pickle and Dry-Cured Meat, and Bacteriocin Identification by Genome Sequencing. LWT 2020, 125, 109177. [Google Scholar] [CrossRef]
- Papadimitriou, K.; Venieraki, A.; Tsigkrimani, M.; Katinakis, P.; Skandamis, P.N. Whole-Genome Sequence Data of the Proteolytic and Bacteriocin Producing Strain Enterococcus Faecalis PK23 Isolated from the Traditional Halitzia Cheese Produced in Cyprus. Data Brief 2021, 38, 107437. [Google Scholar] [CrossRef] [PubMed]
- Rezaei Javan, R.; van Tonder, A.J.; King, J.P.; Harrold, C.L.; Brueggemann, A.B. Genome Sequencing Reveals a Large and Diverse Repertoire of Antimicrobial Peptides. Front. Microbiol. 2018, 9, 2012. [Google Scholar] [CrossRef] [PubMed]
- Barbosa, J.; Albano, H.; Silva, B.; Almeida, M.H.; Nogueira, T.; Teixeira, P. Characterization of a Lactiplantibacillus Plantarum R23 Isolated from Arugula by Whole-Genome Sequencing and Its Bacteriocin Production Ability. Int. J. Environ. Res. Public Health 2021, 18, 5515. [Google Scholar] [CrossRef] [PubMed]
- Taskila, S. Industrial Production of Starter Cultures. In Starter Cultures in Food Production; John Wiley & Sons, Ltd.: Hoboken, NJ, USA, 2017; pp. 79–100. ISBN 978-1-118-93379-4. [Google Scholar]
- Giraud, E.; Lelong, B.; Raimbault, M. Influence of PH and Initial Lactate Concentration on the Growth of Lactobacillus Plantarum. Appl. Microbiol. Biotechnol. 1991, 36, 96–99. [Google Scholar] [CrossRef]
- Partanen, L.; Marttinen, N.; Alatossava, T. Fats and Fatty Acids as Growth Factors for Lactobacillus Delbrueckii. Syst. Appl. Microbiol. 2001, 24, 500–506. [Google Scholar] [CrossRef]
- Morishita, T.; Deguchi, Y.; Yajima, M.; Sakurai, T.; Yura, T. Multiple Nutritional Requirements of Lactobacilli: Genetic Lesions Affecting Amino Acid Biosynthetic Pathways. J. Bacteriol. 1981, 148, 64–71. [Google Scholar] [CrossRef]
- Cocaign-Bousquet, M.; Garrigues, C.; Novak, L.; Lindley, N.d.; Loublere, P. Rational Development of a Simple Synthetic Medium for the Sustained Growth of Lactococcus Lactis. J. Appl. Bacteriol. 1995, 79, 108–116. [Google Scholar] [CrossRef]
- Mora-Villalobos, J.A.; Montero-Zamora, J.; Barboza, N.; Rojas-Garbanzo, C.; Usaga, J.; Redondo-Solano, M.; Schroedter, L.; Olszewska-Widdrat, A.; López-Gómez, J.P. Multi-Product Lactic Acid Bacteria Fermentations: A Review. Fermentation 2020, 6, 23. [Google Scholar] [CrossRef]
- Leroy, F.; De Vuyst, L. Simulation of the Effect of Sausage Ingredients and Technology on the Functionality of the Bacteriocin-Producing Lactobacillus Sakei CTC 494 Strain. Int. J. Food Microbiol. 2005, 100, 141–152. [Google Scholar] [CrossRef]
- Yang, R.; Johnson, M.C.; Ray, B. Novel Method to Extract Large Amounts of Bacteriocins from Lactic Acid Bacteria. Appl. Env. Microbiol. 1992, 58, 3355–3359. [Google Scholar] [CrossRef]
- Leroy, F.; de Vuyst, L. Temperature and PH Conditions That Prevail during Fermentation of Sausages Are Optimal for Production of the Antilisterial Bacteriocin Sakacin, K. Appl. Environ. Microbiol. 1999, 65, 974–981. [Google Scholar] [CrossRef]
- Verluyten, J.; Messens, W.; De Vuyst, L. Sodium Chloride Reduces Production of Curvacin A, a Bacteriocin Produced by Lactobacillus Curvatus Strain LTH 1174, Originating from Fermented Sausage. Appl. Env. Microbiol. 2004, 70, 2271–2278. [Google Scholar] [CrossRef]
- Delgado, A.; Brito, D.; Peres, C.; Noé-Arroyo, F.; Garrido-Fernández, A. Bacteriocin Production by Lactobacillus Pentosus B96 Can Be Expressed as a Function of Temperature and NaCl Concentration. Food Microbiol. 2005, 22, 521–528. [Google Scholar] [CrossRef]
- Schöbitz, R.P.; Bórquez, P.A.; Costa, M.E.; Ciampi, L.R.; Brito, C.S. Bacteriocin like Substance Production by Carnobacterium Piscicola in a Continuous System with Three Culture Broths. Study of Antagonism against Listeria Monocytogenes on Vacuum Packaged Salmon. Braz. J. Microbiol. 2006, 37, 52–57. [Google Scholar] [CrossRef]
- Jack, R.W.; Tagg, J.R.; Ray, B. Bacteriocins of Gram-Positive Bacteria. Microbiol. Rev. 1995, 59, 171–200. [Google Scholar] [CrossRef]
- Wayah, S.B.; Philip, K. Characterization, Yield Optimization, Scale up and Biopreservative Potential of Fermencin SA715, a Novel Bacteriocin from Lactobacillus Fermentum GA715 of Goat Milk Origin. Microb. Cell. Factories 2018, 17, 125. [Google Scholar] [CrossRef]
- Dougherty, B.A.; Hill, C.; Weidman, J.F.; Richardson, D.R.; Venter, J.C.; Ross, R.P. Sequence and Analysis of the 60 Kb Conjugative, Bacteriocin-Producing Plasmid PMRC01 from Lactococcus Lactis DPC3147. Mol. Microbiol. 1998, 29, 1029–1038. [Google Scholar] [CrossRef]
- Weixler, D.; Berghoff, M.; Ovchinnikov, K.V.; Reich, S.; Goldbeck, O.; Seibold, G.M.; Wittmann, C.; Bar, N.S.; Eikmanns, B.J.; Diep, D.B.; et al. Recombinant Production of the Lantibiotic Nisin Using Corynebacterium Glutamicum in a Two-Step Process. Microb. Cell. Factories 2022, 21, 11. [Google Scholar] [CrossRef]
- Weixler, D.; Goldbeck, O.; Seibold, G.M.; Eikmanns, B.J.; Riedel, C.U. Towards Improved Resistance of Corynebacterium Glutamicum against Nisin. bioRxiv 2021, arXiv:2021.08.09.454123. [Google Scholar]
- Goldbeck, O.; Desef, D.N.; Ovchinnikov, K.V.; Perez-Garcia, F.; Christmann, J.; Sinner, P.; Crauwels, P.; Weixler, D.; Cao, P.; Becker, J.; et al. Establishing Recombinant Production of Pediocin PA-1 in Corynebacterium Glutamicum. Metab. Eng. 2021, 68, 34–45. [Google Scholar] [CrossRef] [PubMed]
- Mesa-Pereira, B.; Rea, M.C.; Cotter, P.D.; Hill, C.; Ross, R.P. Heterologous Expression of Biopreservative Bacteriocins with a View to Low Cost Production. Front. Microbiol. 2018, 9, 1654. [Google Scholar] [CrossRef] [PubMed]
- Pérez-Ibarreche, M.; Field, D.; Ross, R.P.; Hill, C. A Bioengineered Nisin Derivative to Control Streptococcus Uberis Biofilms. Appl. Env. Microbiol. 2021, 87, e00391-21. [Google Scholar] [CrossRef] [PubMed]
- European Parliament. Regulation (EC) No 178/2002 of the European Parliament and of the Council of 28 January 2002 Laying Down the General Principles and Requirements of Food Law, Establishing the European Food Safety Authority and Laying Down Procedures in Matters of Food Safety; European Parliament: Strasbourg, France, 2002; Volume 31. [Google Scholar]
- Wessels, S.; Axelsson, L.; Bech Hansen, E.; De Vuyst, L.; Laulund, S.; Lähteenmäki, L.; Lindgren, S.; Mollet, B.; Salminen, S.; von Wright, A. The Lactic Acid Bacteria, the Food Chain, and Their Regulation. Trends Food Sci. Technol. 2004, 15, 498–505. [Google Scholar] [CrossRef]
- Danish Veterinary and Food Administration. List of Notified Microbial Cultures Applied in Food. Oktober 2016. Available online: https://www.foedevarestyrelsen.dk/SiteCollectionDocuments/Kemi%20og%20foedevarekvalitet/Liste%20over%20anmeldte%20mikrobielle%20kulturer%20oktober%202016.pdf (accessed on 25 February 2023).
- European Parliament. Regulation (EU) 2019/1381 of the European Parliament and of the Council of 20 June 2019 on the Transparency and Sustainability of the EU Risk Assessment in the Food Chain and Amending Regulations (EC) No 178/2002, (EC) No 1829/2003, (EC) No 1831/2003, (EC) No 2065/2003, (EC) No 1935/2004, (EC) No 1331/2008, (EC) No 1107/2009, (EU) 2015/2283 and Directive 2001/18/EC (Text with EEA Relevance); European Parliament: Strasbourg, France, 2019; p. 231. [Google Scholar]
- European Parliament. Directive 2009/41/EC of the European Parliament and of the Council of 6 May 2009 on the Contained Use of Genetically Modified Micro-Organisms (Recast) (Text with EEA Relevance); European Parliament: Strasbourg, France, 2009; p. 125. [Google Scholar]
- European Parliament. Regulation (EC) No 1829/2003 of the European Parliament and of the Council of 22 September 2003 on Genetically Modified Food and Feed (Text with EEA Relevance); European Parliament: Strasbourg, France, 2003; p. 268. [Google Scholar]
- European Parliament. Directive 2001/18/EC of the European Parliament and of the Council of 12 March 2001 on the Deliberate Release into the Environment of Genetically Modified Organisms and Repealing Council Directive 90/220/EEC—Commission Declaration; European Parliament: Strasbourg, France, 2001; p. 106. [Google Scholar]
- European Parliament. Regulation (EU) 2015/2283 of the European Parliament and of the Council of 25 November 2015 on Novel Foods, Amending Regulation (EU) No 1169/2011 of the European Parliament and of the Council and Repealing Regulation (EC) No 258/97 of the European Parliament and of the Council and Commission Regulation (EC) No 1852/2001 (Text with EEA Relevance); European Parliament: Strasbourg, France, 2015; p. 327. [Google Scholar]
- European Parliament. Regulation (EC) No 1831/2003 of the European Parliament and of the Council of 22 September 2003 on Additives for Use in Animal Nutrition (Text with EEA Relevance); European Parliament: Strasbourg, France, 2003; p. 268. [Google Scholar]
- European Parliament. Directorate-General Health and Consumer Protection (SANCO) D1(06)D/413447, Summery Record of the Standing Committee on the Food Chain and Animal Health, Held in Brussels on 14 December 2006; European Parliament: Strasbourg, France, 2006. [Google Scholar]
- Stecchini, M.L.; Sarais, I.; de Bertoldi, M. The Influence of Lactobacillus Plantarum Culture Inoculation on the Fate of Staphylococcus Aureus and Salmonella typhimurium in Montasio Cheese. Int. J. Food Microbiol. 1991, 14, 99–109. [Google Scholar] [CrossRef]
- Bolívar, A.; Correia Peres Costa, J.C.; Posada-Izquierdo, G.D.; Bover-Cid, S.; Zurera, G.; Pérez-Rodríguez, F. Quantifying the Bioprotective Effect of Lactobacillus Sakei CTC494 against Listeria Monocytogenes on Vacuum Packaged Hot-Smoked Sea Bream. Food Microbiol. 2021, 94, 103649. [Google Scholar] [CrossRef]
- Juven, B.J.; Pierson, M.D. Antibacterial Effects of Hydrogen Peroxide and Methods for Its Detection and Quantitation. J. Food Prot. 1996, 59, 1233–1241. [Google Scholar] [CrossRef]
- European Parliament. Regulation (EC) No 1333/2008 of the European Parliament and of the Council of 16 December 2008 on Food Additives (Text with EEA Relevance); European Parliament: Strasbourg, France, 2008; Volume 354. [Google Scholar]
- European Parliament. Regulation (EC) No 1332/2008 of the European Parliament and of the Council of 16 December 2008 on Food Enzymes and Amending Council Directive 83/417/EEC, Council Regulation (EC) No 1493/1999, Directive 2000/13/EC, Council Directive 2001/112/EC and Regulation (EC) No 258/97 (Text with EEA Relevance); European Parliament: Strasbourg, France, 2008; Volume 354. [Google Scholar]
- European Parliament. Regulation (EC) No 258/97 of the European Parliament and of the Council of 27 January 1997 Concerning Novel Foods and Novel Food Ingredients; European Parliament: Strasbourg, France, 1997; Volume 43. [Google Scholar]
- European Parliament. Regulation (EC) No 1331/2008 of the European Parliament and of the Council of 16 December 2008 Establishing a Common Authorisation Procedure for Food Additives, Food Enzymes and Food Flavourings (Text with EEA Relevance)Text with EEA Relevance; European Parliament: Strasbourg, France, 2021. [Google Scholar]
- European Parliament. Commission Regulation (EU) No 234/2011 of 10 March 2011 Implementing Regulation (EC) No 1331/2008 of the European Parliament and of the Council Establishing a Common Authorisation Procedure for Food Additives, Food Enzymes and Food Flavourings (Text with EEA Relevance)Text with EEA Relevance; European Parliament: Strasbourg, France, 2021. [Google Scholar]
- EFSA. EFSA Panel on Food Additives and Nutrient Sources added to Food (ANS) Guidance for Submission for Food Additive Evaluations. EFSA J. 2012, 10, 2760. [Google Scholar] [CrossRef]
- Panel, E.B.; Koutsoumanis, K.; Allende, A.; Alvarez-Ordonez, A.; Bolton, D.; Bover-Cid, S.; Chemaly, M.; De Cesare, A.; Hilbert, F.; Lindqvist, R.; et al. Updated List of QPS-Recommended Microorganisms for Safety Risk Assessments Carried Out by EFSA 2023; Wiley: Hoboken, NJ, USA, 2023. [Google Scholar]
- EFSA Panel on Biological Hazards (BIOHAZ); Ricci, A.; Allende, A.; Bolton, D.; Chemaly, M.; Davies, R.; Girones, R.; Herman, L.; Koutsoumanis, K.; Lindqvist, R.; et al. Scientific Opinion on the Update of the List of QPS-Recommended Biological Agents Intentionally Added to Food or Feed as Notified to EFSA. EFSA J. 2017, 15, e04664. [Google Scholar] [CrossRef]
- Laulund, S.; Wind, A.; Derkx, P.M.F.; Zuliani, V. Regulatory and Safety Requirements for Food Cultures. Microorganisms 2017, 5, 28. [Google Scholar] [CrossRef]
- Panel, E.B.; Koutsoumanis, K.; Allende, A.; Alvarez-Ordóñez, A.; Bolton, D.; Bover-Cid, S.; Chemaly, M.; De Cesare, A.; Hilbert, F.; Lindqvist, R.; et al. Microbiological Agents as Notified to EFSA 2023; Wiley: Hoboken, NJ, USA, 2023. [Google Scholar]
- Herman, L.; Chemaly, M.; Cocconcelli, P.S.; Fernandez, P.; Klein, G.; Peixe, L.; Prieto, M.; Querol, A.; Suarez, J.E.; Sundh, I.; et al. The Qualified Presumption of Safety Assessment and Its Role in EFSA Risk Evaluations: 15 Years Past. FEMS Microbiol. Lett. 2019, 366, fny260. [Google Scholar] [CrossRef]
- Federal Food, Drug, and Cosmetic Act, 21 U.S.C. § 301. Available online: https://www.govinfo.gov/content/pkg/USCODE-2021-title21/pdf/USCODE-2021-title21-chap9-subchapII-sec321.pdf (accessed on 25 February 2023).
- Substances Generally Recognized as Safe—Final Rule. Available online: file:///C:/Users/MDPI/Downloads/Substances-Generally-Recognized-as-Safe-(Final-Rule)-Regulatory-Impact-Analysis.pdf (accessed on 25 February 2023).
- Food Additive Petitions, 21 CFR Part 171. Available online: https://www.ecfr.gov/current/title-21/chapter-I/subchapter-B/part-171?toc=1 (accessed on 26 February 2023).
- 21 Food Additives CFR Part 170.30. Available online: https://www.ecfr.gov/current/title-21/chapter-I/subchapter-B/part-170 (accessed on 26 February 2023).
- Nutrition, C. for F.S. and A. Guidance for Industry: Regulatory Framework for Substances Intended for Use in Human Food or Animal Food on the Basis of the Generally Recognized as Safe (GRAS) Provision of the Federal Food, Drug, and Cosmetic Act 2022. Available online: https://www.fda.gov/regulatory-information/search-fda-guidance-documents/guidance-industry-regulatory-framework-substances-intended-use-human-food-or-animal-food-basis (accessed on 26 February 2023).
- Generally Recognized as Safe (GRAS) Notice, 21 CFR Part 170 Subpart E. Available online: https://www.ecfr.gov/current/title-21/chapter-I/subchapter-B/part-170/subpart-E?toc=1 (accessed on 25 February 2023).
- AMEPRES. Probiótica, Suplementos Alimenticios y Alimentos Funcionales. Las Diferencias y Semejanzas, Así Como Su Entorno Regulatorio. Available online: https://amepresmexico.org.mx/wp-content/uploads/2018/07/Boletin-No14_OK.pdf (accessed on 31 March 2023).
- Gência Nacional de Vigilância Sanitária—Anvisa. Resolution RDC 27/2010: Categories of Foods and Packaging That Require a Pre-Market Approval by Anvisa; 2010; Volume RDC. Available online: http://antigo.anvisa.gov.br/legislacao#/visualizar/28564 (accessed on 31 March 2023).
- National Health Commission China. List of Strains That Can Be Used in Foods; 2022. Available online: http://www.nhc.gov.cn/sps/s7892/202208/1d6c229d6f744b35827e98161c146afb/files/f7177b32d93142f9827dcc55fb6889c2.pdf?_x_tr_sl=auto&_x_tr_tl=de&_x_tr_hl=de&_x_tr_pto=wapp&_x_tr_sch=http (accessed on 31 March 2023).
- Ministry of Public Health Thailand. Volume 133, Special Part 298, Government Gazette, 20 December 2016, Notification of the Ministry of Public Health (No. 381) B.E. 2559 on Food Additives (No. 4) 2016. Available online: http://food.fda.moph.go.th/law/data/announ_moph/P381.pdf (accessed on 31 March 2023).
- LAWS OF MALAYSIA. Regulation No.437—1985 Malaysian Food Act Version of 2014. Available online: https://importlicensing.wto.org/sites/default/files/members/91/Regulation%20No.437%20-%20Food%201985_01.01.2014.pdf (accessed on 31 March 2023).
- Future Market Insights. Food and Beverage Protective Cultures Market. 2022. Available online: https://www.futuremarketinsights.com/reports/food-and-beverage-protective-cultures-market (accessed on 26 February 2023).
- Grunert, K.G. Food Quality and Safety: Consumer Perception and Demand. Eur. Rev. Agric. Econ. 2005, 32, 369–391. [Google Scholar] [CrossRef]
- Inglin, R.C.; Delbrück, A.I.; Fässler, B.; Siebenmann, K.E.; Lacroix, C.; Stevens, M.J.A.; Meile, L. An Approach to Select Lactobacillus Isolates as Protective Cultures for Food Fermentations. J. Food Saf. 2018, 38, e12483. [Google Scholar] [CrossRef]
- Xu, M.M.; Kaur, M.; Pillidge, C.J.; Torley, P.J. Effect of Protective Cultures on Spoilage Bacteria and the Quality of Vacuum-Packaged Lamb Meat. Food Biosci. 2022, 50, 102148. [Google Scholar] [CrossRef]
- Xu, M.M. Protective Cultures as Natural Antimicrobials for Fresh Meat Shelf-Life Extension: Their Application and Consumer Acceptance. Ph.D. Thesis, RMIT University, Melbourne, VIC, Australia, 2022. [Google Scholar]
- Kim, C.R.; Hearnsberger, J.O.; Vickery, A.P.; White, C.H.; Marshall, D.L. Sodium Acetate and Bifidobacteria Increase Shelf-Life of Refrigerated Catfish Fillets. J. Food Sci. 1995, 60, 25–27. [Google Scholar] [CrossRef]
- Dopazo, V.; Luz, C.; Mañes, J.; Quiles, J.M.; Carbonell, R.; Calpe, J.; Meca, G. Bio-Preservative Potential of Microorganisms Isolated from Red Grape against Food Contaminant Fungi. Toxins 2021, 13, 412. [Google Scholar] [CrossRef]
- Le, N.T.T.; Bach, L.G.; Nguyen, D.C.; Le, T.H.X.; Pham, K.H.; Nguyen, D.H.; Hoang Thi, T.T. Evaluation of Factors Affecting Antimicrobial Activity of Bacteriocin from Lactobacillus Plantarum Microencapsulated in Alginate-Gelatin Capsules and Its Application on Pork Meat as a Bio-Preservative. Int. J. Environ. Res. Public Health 2019, 16, 1017. [Google Scholar] [CrossRef]
- Mordor Intelligence. Marktanalyse für Schutzkulturen, Größe, Anteil (2022—2027); Mordor Intelligence: Telangana, India, 2022. [Google Scholar]
- MDF ltd. Protective Cultures Market Size, Growth, Share | 2023–2028; Market Data Forecast: Telangana, India, 2022. [Google Scholar]

| Ingredient | Source |
|---|---|
| carbohydrate | glucose or lactose (skim)milk or whey cellobiose–xylose mixture) sugar molasses |
| amino acids or peptones | mainly added though peptones, yeast extracts or proteins (milk) |
| fatty acids | tween, acetate |
| nucleosides/nucleotides | yeast extracts, meat |
| minerals | mainly added as salts |
| vitamins | yeast extracts, meat extracts, and peptones |
| citrate | purified dairy-based ingredient |
| Category | Category No. | Maximum Quantity | Restriction/Place of Use |
|---|---|---|---|
| other cream products | 01.6.3 | 10 mg/L bzw. mg/kg | clotted cream products |
| unripened cheese, (except products of category 16) | 01.7.2 | 10 mg/L or mg/kg | mascarpone |
| ripened cheese | 01.7.2 | 12.5 mg/L or mg/kg | |
| processed cheese | 01.7.5 | 12.5 mg/L or mg/kg | |
| cheese products (except category 16) | 01.7.6 | 12.5 mg/L or mg/kg | ripened and processed products only |
| eggs and egg products processed | 10.2 | 6.25 mg/L or mg/kg | pasteurized liquid only (egg white, yolk or whole egg) |
| dessert foods, excluding products of categories 1, 3 and 4 | 16 | 3 mg/L or mg/kg | semolina and tapioca puddings and similar products only |
| GRAS | QPS |
|---|---|
| food additives and microorganisms | microorganisms only |
| FDA or external experts determine GRAS status | EFSA determines QPS status |
| open to all types of food additives | limited to microorganisms associated with regulated food and feed products only |
| applicants request a GRAS status | EFSA requests evaluation of new taxonomic units within the scope of an internal mandate |
| describes a specific substance or microorganism at the strain level | describes microorganisms at the taxonomic unit level |
| case-by-case safety assessment at the strain level | general safety assessment at the taxonomic unit level. |
| open tool to all applicants | internal tool by EFSA |
| Food Application | Product Name | Microorganism | Manufacturer |
|---|---|---|---|
| Fish & fish products | Lyoflora FP-18 | Carnobacterium spp. | SACCO |
| Lyoflora FP-50 | Carnobacterium spp. | SACCO | |
| Meat & sausage products | AVO raw sausage protective culture | Lactobacillus plantarum | AVO-Werke August Beisse GmbH |
| Lyocarni BMX-37 | Carnobacterium spp., Lactobacillus sakei | SACCO | |
| Lyocarni BOM-13 | Carnobacterium spp., Lactobacillus sakei | SACCO | |
| Lyocarni BOX-74 | Carnobacterium spp., Lactobacillus sakei | SACCO | |
| Lyocarni BXH-69 | Carnobacterium spp., Lactobacillus sakei | SACCO | |
| Lyoflora FP-18 | Carnobacterium spp. | SACCO | |
| Lyoflora FP-50 | Carnobacterium spp | SACCO | |
| M-Culture RS 103 | Lactobacillus curvatus subsp. curvatus, Lactobacillus plantarum, Lactobacillus sakei, Staphylococcus carnosus | M-Foodgroup GmbH | |
| M-Culture RS 107 | Lactobacillus curvatus subsp. curvatus, Lactobacillus plantarum, Lactobacillus sakei, Staphylococcus carnosus | M-Foodgroup GmbH | |
| M-Culture RS 38 | Lactobacillus curvatus subsp. curvatus, Lactobacillus plantarum, Pediococcus pentosaceus, Staphylococcus carnosus, Staphylococcus xylosus, Debaryomyces hansenii | M-Foodgroup GmbH | |
| M-Culture RS 49 FM | Debaryomyces hansenii, Lactobacillus sakei, Lactobacillus plantarum | M-Foodgroup GmbH | |
| M-Culture Safe GDS 3349 | Leuconostoc Carnosum | M-Foodgroup GmbH | |
| ProtectSTART | Staphylococcus xylosus, Staphylococcus carnosus, Leuconostoc citreum | Moguntia food group | |
| SaferSTART | Leuconostoc citeum | Moguntia food group | |
| Protective cultures for raw sausage | Lactobacillus sakai, Pediococcus pentosaceus, Staphylococcus xylosus, Staphylococcus carnosus, Debaryomyces hansenii | Würzteufel GmbH | |
| Protective culture Ham-Protect | Lactobacillus plantarum, Staphylococcus carnosus, Staphylococcus xylosus | Würzteufel GmbH | |
| Meat & sausage products | Protective culture PROTECT ONE | Staphylococcus xylosus, Staphylococcus carnosus, Lactobacillus plantarum bac+ | Würzteufel GmbH |
| StartStar SAFE Protective Cultures | unknown culture with Bacteriocin producer | Holkof GmbH | |
| Milk & dairy products | AC line DY 4P13 | unknown mixture of LAB | SACCO |
| AC line LC 4P1 | unknown mixture of LAB | SACCO | |
| AC line LCP 4P2 | unknown mixture of LAB | SACCO | |
| AC line MO K4P04 | unknown mixture of LAB without Lactococcus lactis | SACCO | |
| AC line MO L4P03 | unknown mixture of LAB without Lactococcus lactis | SACCO | |
| AC line MO N4P01 | unknown mixture of LAB with Lactococcus lactis as nisin producer | SACCO | |
| AC line MO N4P02 | unknown mixture of LAB with Lactococcus lactis as nisin producer | SACCO | |
| AL line CNBAL | unkown mixture of LAB with Carnobacterium divergens V41 and Carnobacterium piscicola SF668 | SACCO | |
| AL line LPAL | unknown mixture of LAB | SACCO | |
| AOSM line BGP1 | unknown mixture of LAB | SACCO | |
| AOSM line LR B | unknown mixture of LAB with Lactobacillus rhamnosus | SACCO | |
| AYM line CLP C | unknown mixture of LAB | SACCO | |
| AYM line LPR A | unknown mixture of LAB | SACCO | |
| AYM line LR B | unknown mixture of LAB with Lactobacillus rhamnosus | SACCO | |
| AYM line LR4 PD | unknown mixture of LAB | SACCO | |
| BIOPROX CP63 | Lactobacillus rhamnosus, Lactiplantibacillus plantarum | bioprox | |
| BIOPROX L135 | Lactococcus lactis | bioprox | |
| BIOPROX P 83 | Lactiplantibacillus plantarum | bioprox | |
| BIOPROX P 94 | Lactobacillus plantarum subsp. Plantarum | bioprox | |
| BIOPROX RP 80 | Lactobacillus rhamnosus, Lactiplantibacillus plantarum | bioprox | |
| BIOPROX SP 86 | Limosilactobacillus fermentum | bioprox | |
| BIOPROX Z100 | Lactiplantibacillus plantarum | bioprox | |
| BS-10 | Lactococcus lactis subsp. lactis | CHR Hansen | |
| FreshQ 11 | Lactobacillus rhamnosus | CHR Hansen | |
| FreshQ 2 | Lactobacillus rhamnosus | CHR Hansen | |
| FreshQ 4 | Lactobacillus rhamnosus | CHR Hansen | |
| FreshQ Cheese 1 | Lactobacillus rhamnosus | CHR Hansen | |
| HOLDBAC GP10 | Pediococcus acidilactici | IFF | |
| Milk & dairy products | HOLDBAC GP20 FRO 500DCU | Lactococcus lactis subsp. lactis (nisin producer), Lactobacillus paracasei, Lactobacillus plantarum | IFF |
| HOLDBAC GP21 FRO 500DCU | Lactococcus lactis subsp. lactis (nisin producer), Lactobacillus rhamnosus, Lactobacillus plantarum | IFF | |
| HOLDBAC LC | Lactobacillus rhamnosus | IFF | |
| Holdbac LC Lyo 100 DCU—Schutzkultur | Lactobacillus rhamnosus | DANISCO (IFF) | |
| HOLDBAC Listeria | Lactobacillus plantarum | IFF | |
| Holdbac YM-B | Lactobacillus rhamnosus, Propionibacterium freudenreichii subsp. Shermanii | IFF | |
| Holdbac YM-B LYO 100 DCU—Schutzkultur | Lactobacillus rhamnosus, Propionibacterium freudenreichii subsp. shermanii | DANISCO (IFF) | |
| HOLDBAC YM-C | Lactobacillus paracasei, Propionibacterium freudenreichii subsp. Shermanii | IFF | |
| HOLDBAC YM-C PLUS | Propionibacterium freudenreichii, Lactobacillus paracasei | IFF | |
| HOLDBAC YM-SUSTAIN | Lactobacillus plantarum, Lactobacillus paracasei | IFF | |
| HOLDBAC YM-XPK | Lactobacillus plantarum | IFF | |
| HOLDBAC YM-XPM | Lactobacillus plantarum, Lactobacillus paracasei | IFF | |
| HOLDBAC YM-XTEND | Lactobacillus plantarum, Lactobacillus rhamnosus | IFF | |
| LC|100 DCU | Lactobacillus rhamnosus | DANISCO (IFF) | |
| Pure Appeal 01 | Lactobacillus paracasei, Streptococcus thermophilus | CHR Hansen | |
| YM-B|100 DCU | Lactobacillus rhamnosus, Propionibacterium freudenreichii subsp. Shermanii | DANISCO (IFF) | |
| vegan products in general | HOLDBAC YM-VEGE | Propionibacterium freudenreichii subsp. shermanii, Lactobacillus rhamnosus | IFF |
| Vega FreshQ 101 | Lactobacillus rhamnosus | CHR Hansen | |
| Vega SafePro 01 data | Lactobacillus sakei | CHR Hansen | |
| Vegan meat & sausage alternatives | Safe M-Culture Vegan | Leuconostoc carnosum | M-Foodgroup GmbH |
| Protective culture PROTECT ONE | Staphylococcus xylosus, Staphylococcus carnosus, Lactobacillus plantarum bac+ | Würzteufel GmbH | |
| Vegan milk & dairy alternatives | Lyofast BGP 1 | unknown mixture of LAB | SACCO |
| Lyofast CLP C | unknown mixture of LAB | SACCO | |
| Vegan milk & dairy alternatives | Lyofast CNBAL | unknown mixture of LAB with Carnobacterium divergens V41 and Carnobacterium piscicola SF668 | SACCO |
| Lyofast LPAL | unknown mixture of LAB | SACCO | |
| Lyofast LPR A | unknown mixture of LAB | SACCO | |
| Lyofast BGP 1 | unknown mixture of LAB with Lactobacillus rhamnosus | SACCO | |
| Lyofast CLP C | unknown mixture of LAB | SACCO | |
| Lyofast LR B | unknown mixture of LAB | SACCO | |
| Lyofast LR4 PD | unknown mixture of LAB | SACCO |
Disclaimer/Publisher’s Note: The statements, opinions and data contained in all publications are solely those of the individual author(s) and contributor(s) and not of MDPI and/or the editor(s). MDPI and/or the editor(s) disclaim responsibility for any injury to people or property resulting from any ideas, methods, instructions or products referred to in the content. |
© 2023 by the authors. Licensee MDPI, Basel, Switzerland. This article is an open access article distributed under the terms and conditions of the Creative Commons Attribution (CC BY) license (https://creativecommons.org/licenses/by/4.0/).
Share and Cite
Fischer, S.W.; Titgemeyer, F. Protective Cultures in Food Products: From Science to Market. Foods 2023, 12, 1541. https://doi.org/10.3390/foods12071541
Fischer SW, Titgemeyer F. Protective Cultures in Food Products: From Science to Market. Foods. 2023; 12(7):1541. https://doi.org/10.3390/foods12071541
Chicago/Turabian StyleFischer, Sebastian W., and Fritz Titgemeyer. 2023. "Protective Cultures in Food Products: From Science to Market" Foods 12, no. 7: 1541. https://doi.org/10.3390/foods12071541
APA StyleFischer, S. W., & Titgemeyer, F. (2023). Protective Cultures in Food Products: From Science to Market. Foods, 12(7), 1541. https://doi.org/10.3390/foods12071541

